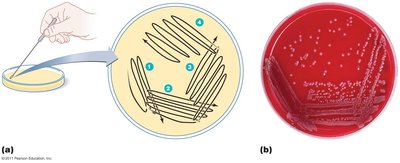
Streak plate method diagram and result
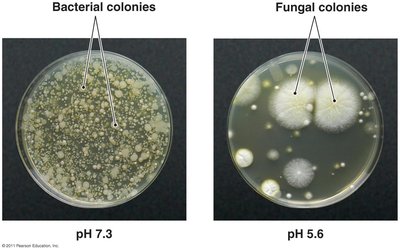
Selective medium example
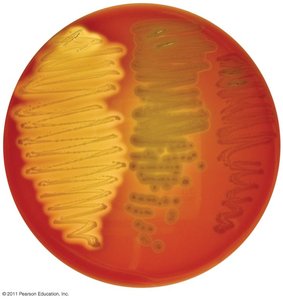
Blood agar as a differential medium
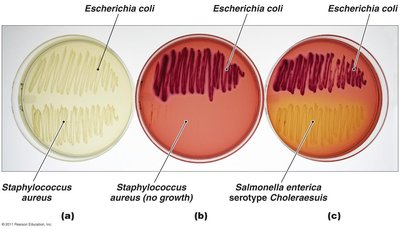
MacConkey agar as selective and differential medium

BackMicrobial Nutrition, Growth, and Culturing: Study Notes
Study Guide - Smart Notes
Tailored notes based on your materials, expanded with key definitions, examples, and context.
Microbial Nutrition and Growth Requirements
Overview of Microbial Growth
Microbial growth refers to the increase in a population of microbes, typically resulting in the formation of discrete colonies. These colonies arise from a single parent cell, and reproduction is the primary mechanism driving growth.
Colony: An aggregation of cells originating from one parent cell.
Growth: Increase in cell number, not cell size.
Essential Nutrients for Microbial Growth
Microorganisms require a variety of nutrients to meet their energy needs and to build cellular structures. The most common nutrients contain elements such as carbon, oxygen, nitrogen, and hydrogen.
Carbon, Oxygen, Nitrogen, Hydrogen: Fundamental elements for cellular function.
Nutrient Sources: Microbes obtain nutrients from diverse sources, including organic and inorganic compounds.
Chemical and Energy Requirements
Microbes are classified based on their sources of carbon and energy. These classifications help understand their ecological roles and metabolic capabilities.
Carbon Source: Autotrophs (use CO2), Heterotrophs (use organic compounds).
Energy Source: Chemotrophs (chemical compounds), Phototrophs (light).

Oxygen Requirements
Oxygen is essential for some microbes but toxic for others. The toxicity is due to highly reactive forms of oxygen that cause cellular damage.
Obligate Aerobes: Require oxygen for survival.
Obligate Anaerobes: Oxygen is lethal.
Facultative Anaerobes: Can survive with or without oxygen.
Aerotolerant Anaerobes: Tolerate oxygen but do not use it.
Microaerophiles: Require low oxygen concentrations.

Toxic Forms of Oxygen
Four toxic forms of oxygen include singlet oxygen, superoxide radicals, peroxide anion, and hydroxyl radical. These forms are highly reactive and can cause irreparable damage to cellular components.
Catalase Test: Used to detect the presence of catalase enzyme, which breaks down hydrogen peroxide.

Nitrogen and Other Chemical Requirements
Nitrogen is vital for anabolism and is acquired from organic and inorganic sources. Other essential elements include phosphorus, sulfur, and trace elements. Growth factors are organic chemicals that some organisms cannot synthesize and must obtain from the environment.
Nitrogen Fixation: Certain bacteria convert atmospheric nitrogen into usable forms, essential for life.
Trace Elements: Required in minute amounts for enzyme function.
Growth Factors: Vitamins, amino acids, purines, and pyrimidines.
Physical Requirements for Microbial Growth
Temperature
Temperature affects microbial growth by influencing protein stability and membrane fluidity. Microbes are classified based on their optimal growth temperatures.
Psychrophiles: Grow best at low temperatures (below 20°C).
Mesophiles: Grow best at moderate temperatures (20–40°C).
Thermophiles: Grow best at high temperatures (above 45°C).
Hyperthermophiles: Grow best at extremely high temperatures (above 80°C).



pH
Microbes are sensitive to pH changes, which affect hydrogen bonding and enzyme activity. They are classified based on their preferred pH range.
Neutrophiles: Grow best at neutral pH (6.5–7.5).
Acidophiles: Grow best in acidic environments.
Alkalinophiles: Grow best in alkaline environments.
Water and Its Physical Effects
Water is essential for dissolving nutrients and enzymes and is a reactant in many metabolic reactions. Two key physical effects of water are osmotic pressure and hydrostatic pressure.
Osmotic Pressure: Pressure exerted by solutes across a semipermeable membrane. Hypotonic solutions have lower solute concentrations; hypertonic solutions have higher solute concentrations.
Halophiles: Microbes that require high salt concentrations.
Hydrostatic Pressure: Pressure exerted by water at depth. Barophiles thrive under extreme pressure.
Microbial Associations and Biofilms
Types of Microbial Relationships
Microbes often live in association with other species, forming antagonistic, synergistic, or symbiotic relationships.
Antagonistic: One organism harms another.
Synergistic: Cooperative interactions benefit all participants.
Symbiotic: Close, long-term interactions.
Biofilms
Biofilms are complex communities of microorganisms that develop an extracellular matrix, adhere to surfaces, and protect individual cells. Biofilms often form as a result of quorum sensing and are more harmful than individual microbes.
Extracellular Matrix: Provides structural support and protection.
Quorum Sensing: Cell-to-cell communication regulating biofilm formation.

Culturing Microorganisms
Obtaining Pure Cultures
Pure cultures are composed of cells from a single progenitor, known as a colony-forming unit (CFU). Aseptic techniques prevent contamination. Common isolation methods include streak plates and pour plates.
Streak Plate: Method for isolating pure colonies.
Pour Plate: Dilution method for isolating colonies.

Culture Media Types
Culture media are used to grow microorganisms in the laboratory. There are six general types:
Defined Media: Exact chemical composition is known.
Complex Media: Contains nutrients from partial digestion of yeast, beef, soy, or proteins.
Selective Media: Favors growth of particular microbes.
Differential Media: Distinguishes between different microbes.
Anaerobic Media: Supports growth of anaerobes.
Transport Media: Maintains and preserves specimens during transport.

Special Culture Techniques
Special techniques are used for culturing fastidious or unculturable microorganisms, including animal and cell culture, low-oxygen culture, and enrichment culture.

Preserving Cultures
Microbial cultures can be preserved by refrigeration (short-term), deep-freezing (years), or lyophilization (decades).
Growth of Microbial Populations
Binary Fission
Most bacteria reproduce by binary fission, a process in which a cell divides into two identical daughter cells.
Binary Fission Steps: Chromosome replication, cell elongation, septum formation, cell separation.

Generation Time
Generation time is the period required for a bacterial cell to grow and divide. It depends on environmental conditions.
Microbial Growth Curve
A typical microbial growth curve consists of four phases: lag, log (exponential), stationary, and death (decline).
Lag Phase: Cells adjust to environment.
Log Phase: Rapid cell division.
Stationary Phase: Nutrient depletion slows growth.
Death Phase: Cells die due to lack of nutrients and accumulation of waste.

Measuring Microbial Reproduction and Growth
Direct Methods
Direct methods for measuring microbial reproduction include serial dilution and viable plate counts, membrane filtration, most probable number (MPN), microscopic counts, and electronic counters.
Serial Dilution and Plate Count: Dilute sample and count colonies.
Membrane Filtration: Filter sample, incubate filter on medium, count colonies.
MPN: Statistical estimation based on dilution and positive growth.
Microscopic Counts: Count cells under microscope.
Electronic Counters: Automated cell counting.




Indirect Methods
Indirect methods include measuring metabolic activity, dry weight, and turbidity. These methods estimate population size without directly counting cells.
Metabolic Activity: Measure production of metabolic products.
Dry Weight: Weigh dried cells.
Turbidity: Measure cloudiness of culture using a spectrophotometer.

Genetic Methods
Genetic methods involve isolating DNA sequences from unculturable prokaryotes to estimate their numbers in environmental samples.
Summary Table: Microbial Nutritional Types
Carbon Source | Energy Source | Type | Examples |
|---|---|---|---|
CO2 (auto-) | Light (photo-) | Photoautotrophs | Plants, algae, cyanobacteria |
CO2 (auto-) | Chemical compounds (chemo-) | Chemoautotrophs | Hydrogen, sulfur, nitrifying bacteria |
Organic compounds (hetero-) | Light (photo-) | Photoheterotrophs | Green nonsulfur bacteria, purple nonsulfur bacteria |
Organic compounds (hetero-) | Chemical compounds (chemo-) | Chemoheterotrophs | Most animals, fungi, protozoa, many bacteria |
Key Equations
Generation Time Equation:
Exponential Growth Equation:
Where = number of cells at time , = initial number of cells, = number of generations.
Additional info: Academic context and explanations have been expanded for clarity and completeness. All images included are directly relevant to the adjacent content.